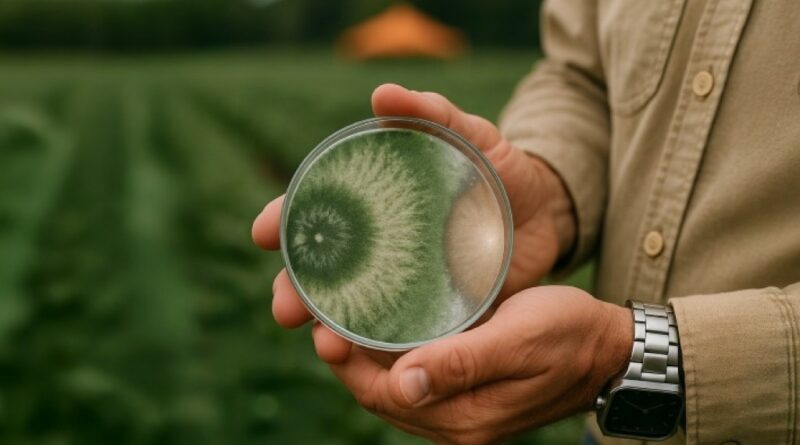

Trichoderma ESALQ 1306 aumenta produtividade do milho em até 60% mesmo sob seca, revela estudo internacional
Estudo internacional comprova eficácia do Trichoderma no milho
Um estudo internacional liderado pela Universidade Tecnológica Federal do Paraná (UTFPR) demonstrou que a cepa Trichoderma harzianum ESALQ 1306 pode aumentar a produtividade do milho em até 60% mesmo em condições de déficit hídrico.
A pesquisa contou com a participação de instituições brasileiras e internacionais, incluindo a Universidade Estadual do Mato Grosso do Sul (UEMS), Unesp, Embrapa, a University of Antwerp (Bélgica) e a Princess Nourah University (Arábia Saudita).
O artigo, intitulado “Mitigating drought effects in maize with Trichoderma harzianum (strain ESALQ 1306): a bioinoculant for sustainable agriculture”, está disponível neste link. https://pse.agriculturejournals.cz/artkey/pse-202510-0005_mitigating-drought-effects-in-maize-with-trichoderma-harzianum-strain-8211-esalq-1306-a-bioinoculant-for.php
Como a cepa melhora a produtividade do milho
O segredo do desempenho da ESALQ 1306 está no estímulo ao crescimento radicular, ampliando a área de absorção de água e nutrientes do solo. Isso aumenta a tolerância das plantas ao estresse hídrico, garantindo maior consistência e uniformidade na lavoura.
Além disso, a cepa oferece controle biológico eficiente contra nematoides e patógenos do solo, combinando proteção e bioestimulação em um único organismo vivo.
Thiago Castro, gerente de P&D da Koppert Brasil, destaca:
“A cepa ESALQ 1306 traduz ciência de ponta em performance agronômica. Ao fortalecer o sistema radicular e mitigar o impacto da seca, ela entrega produtividade com resiliência, exatamente o que o agricultor precisa.”
Colaboração científica e validação internacional
O estudo reuniu diversos pesquisadores, como Renato Lustosa Sobrinho, técnico da UEMS e pesquisador associado na University of Antwerp, e Prof.ª Dra. Taciane Finatto, entre outros especialistas brasileiros e internacionais.
A pesquisa reforça a autoridade tecnológica da Koppert e consolida a ESALQ 1306 como ferramenta estratégica para uma agricultura sustentável e de alta performance, especialmente em cenários de variabilidade climática e estresse hídrico.
Da ciência para o campo
Desenvolvida em parceria com a Escola Superior de Agricultura “Luiz de Queiroz” (ESALQ/USP), a cepa integra o portfólio da Koppert Brasil e é compatível com práticas de manejo consolidadas, como tratamento de sementes, manejo de solo, nutrição equilibrada e rotação de culturas.
Segundo Castro:
“Soluções biológicas com base científica sólida respondem a riscos como clima, sanidade e eficiência de insumos. Nosso papel é conectar essa evidência à operação do produtor, gerando resultados reais com responsabilidade e sustentabilidade.”
Fonte: Portal do Agronegócio
Fonte: Portal do Agronegócio